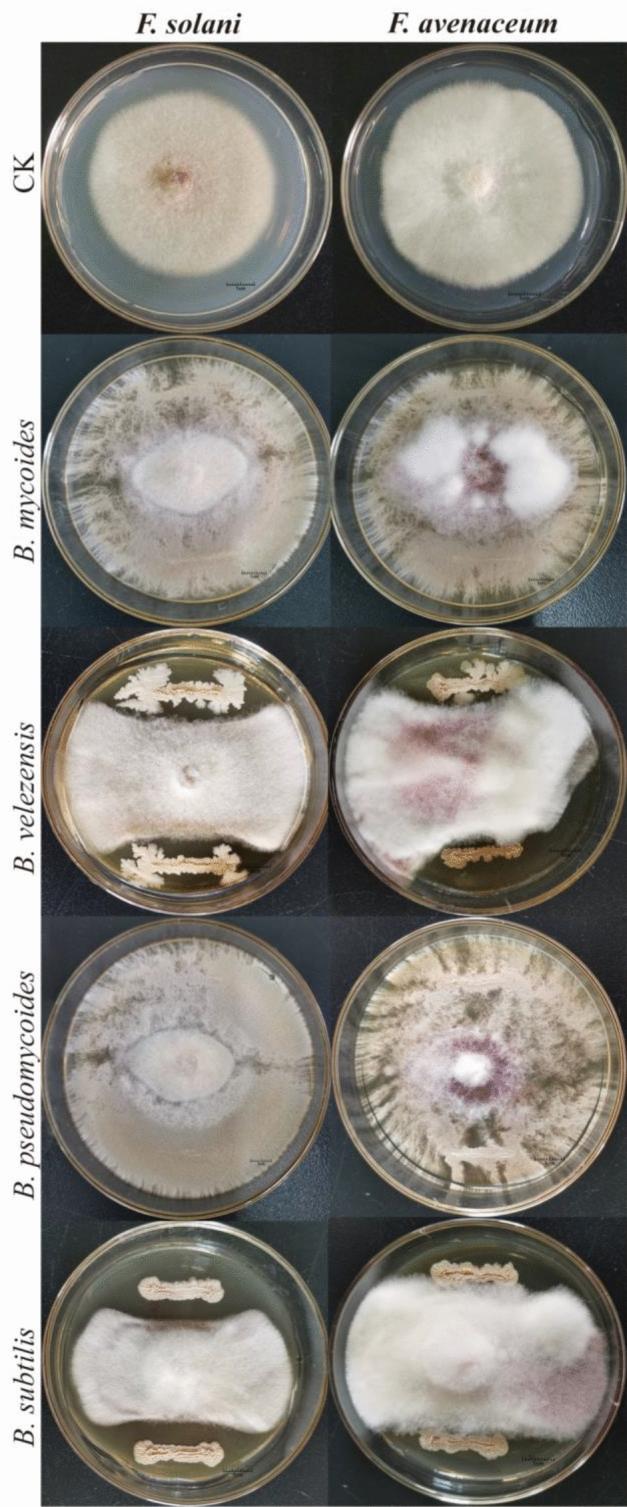
https://cdn.ncbi.nlm.nih.gov/pmc/blobs/66e1/8160328/c08219f9dde6/41598_2021_90489_Fig7_HTML.jpg

高通量测序辅助快速鉴定与黄连根腐病相关的病原和拮抗微生物。
Auxiliary rapid identification of pathogenic and antagonistic microorganisms associated with Coptis chinensis root rot by high-throughput sequencing.
机构信息
State Key Laboratory Breeding Base of Systematic Research, Development and Utilization of Chinese Medicine Resources, Chengdu University of Traditional Chinese Medicine, Chengdu, 611137, China.
Department of Pharmacy, Chengdu University of Traditional Chinese Medicine, Chengdu, 611137, China.
出版信息
Sci Rep. 2021 May 27;11(1):11141. doi: 10.1038/s41598-021-90489-9.
Root rot reduces the yield and medical quality of C. chinensis (Cc). Previous studies of Coptis root rot focused on the identification of pathogens and the rhizosphere microbial community composition. The present study aimed to identify potential pathogenic and antagonistic microorganisms associated with root rot based on a high-throughput sequencing technique to prevent this disease. Healthy and diseased Cc in the endosphere and rhizosphere from the same field were collected to investigate the differences in microbiome composition and function. The results showed that the composition and function of microbes were different. The numbers of animal pathogens, soil saprotrophs, plant saprotrophs, and wood saprotrophs in the endosphere of diseased Cc were higher than those in the healthy endosphere and were dominated by Phaeosphaeriaceae, Cladorrhinum, Fusarium, Exophiala, and Melanommataceae. Fusarium, Volutella, Cladorrhinum, Cylindrocarpon, and Exophiala were significantly enriched in the endosphere of the diseased plants. Co-occurrence network analysis showed that Bacillus was negatively correlated with Fusarium, Volutella, and Cylindrocarpon, indicating that Bacillus may be antagonistic microorganisms. To verify the sequencing results, F. solani and F. avenaceum were isolated and verified as pathogens, and 14 Bacillus strains were isolated, which displayed an apparent suppression effect against the two pathogens on PDA medium and detached roots. The strategy of high-throughput sequencing has the potential for the comprehensive identification of pathogenic and antagonistic microorganisms for plant disease. These results provide research ideas and microbial resources for future studies on mitigating or preventing root rot damage to Cc.
根腐病降低了黄连( C. chinensis )的产量和药用品质。先前对黄连根腐病的研究主要集中在病原体的鉴定和根际微生物群落组成上。本研究旨在通过高通量测序技术,识别与根腐病相关的潜在致病和拮抗微生物,以预防这种疾病。从同一田间采集健康和患病的黄连内生和根际样本,以研究微生物群落组成和功能的差异。结果表明,微生物的组成和功能存在差异。患病黄连内生动物病原体、土壤腐生菌、植物腐生菌和木质腐生菌的数量高于健康内生,优势属为 Phaeosphaeriaceae 、 Cladorrhinum 、 Fusarium 、 Exophiala 和 Melanommataceae 。 Fusarium 、 Volutella 、 Cladorrhinum 、 Cylindrocarpon 和 Exophiala 在患病植物的内生区明显富集。共现网络分析表明,芽孢杆菌与 Fusarium 、 Volutella 和 Cylindrocarpon 呈负相关,表明芽孢杆菌可能是拮抗微生物。为了验证测序结果,分离并验证了 F. solani 和 F. avenaceum 为病原体,并分离出 14 株芽孢杆菌,它们在 PDA 培养基和离体根上对这两种病原体表现出明显的抑制作用。高通量测序策略有望全面鉴定植物病害的致病和拮抗微生物。这些结果为未来研究减轻或预防黄连根腐病损害提供了研究思路和微生物资源。